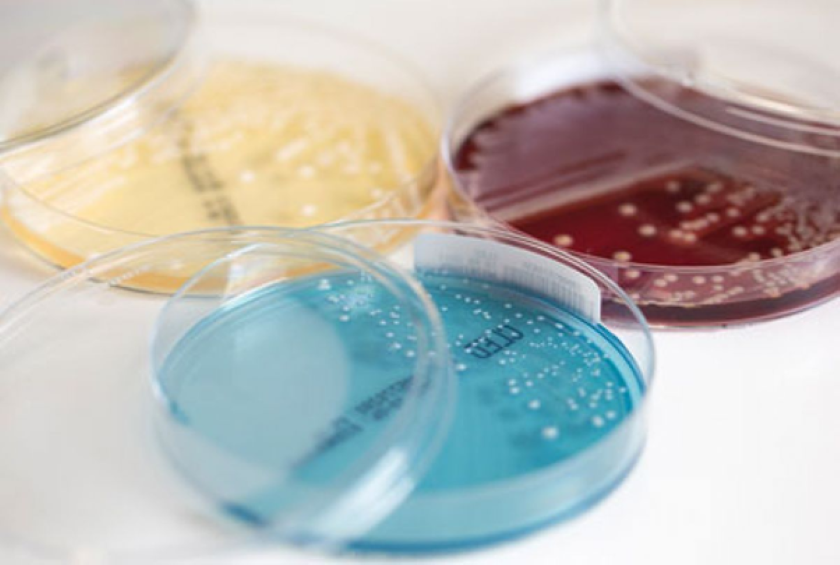

Antimicrobial resistance and therapy - deze pagina niet meer bewerken
&width=826&height=464)
Complex Urine Tract Infections
Urinary tract infection (UTI) is one of the most common bacterial infections, and the most common reason for antibiotic prescriptions.
In collaboration with the department of Urology LUMC and the HAGA teaching hospital (dr. C van Nieuwkoop), UTI patient care is combined with applied research for new diagnostic and therapeutic methods through a multidisciplinary approach.
We focus on (recurrent) UTI due to (particularly) resistant micro-organisms (BRMO), UTI in patients after renal transplantation, the role of the microbioma and complications of antibiotic therapy such as Clostridioides difficile infections.
…Urinary tract infection (UTI) is one of the most common bacterial infections, and the most common reason for antibiotic prescriptions.
In collaboration with the department of Urology LUMC and the HAGA teaching hospital (dr. C van Nieuwkoop), UTI patient care is combined with applied research for new diagnostic and therapeutic methods through a multidisciplinary approach.
We focus on (recurrent) UTI due to (particularly) resistant micro-organisms (BRMO), UTI in patients after renal transplantation, the role of the microbioma and complications of antibiotic therapy such as Clostridioides difficile infections.
The LUMC participates in several clinical trials, investigating decolonization of BRMO carriage in patients after renal transplantation, finding new biomarkers for diagnosing UTI (SENIOR study), prevention of UTI with bladder irrigations/vaccination, and treatment of UTI with Fosfomycin in men.
Biofilms, antimicrobial peptides and bacteriophages
Antimicrobial peptides (AMPs) and bacteriophages may offer a solution for treatment of drug-resistant infections in this era of antimicrobial resistance. The effect of antimicrobial peptides is based, among other things, on disruption of the cell membrane that surrounds the bacterium. Selected variant peptides eradicate all bacteria, including those that are resistant or tolerant to antibiotics, even bacteria within a mature biofilm.
Promising strategies including bacteriophages and antimicrobial peptides are being tested for their efficacy against biofilm associated infections caused by different pathogens. We will test the safety and effectiveness of candidate peptides in humans.
…Antimicrobial peptides (AMPs) and bacteriophages may offer a solution for treatment of drug-resistant infections in this era of antimicrobial resistance. The effect of antimicrobial peptides is based, among other things, on disruption of the cell membrane that surrounds the bacterium. Selected variant peptides eradicate all bacteria, including those that are resistant or tolerant to antibiotics, even bacteria within a mature biofilm.
Promising strategies including bacteriophages and antimicrobial peptides are being tested for their efficacy against biofilm associated infections caused by different pathogens. We will test the safety and effectiveness of candidate peptides in humans.
This research is closely connected with our clinical and epidemiological research regarding biofilm-associated infections, e.g. prosthetic joint infection and fracture-related infection (www.protheseinfectie.nl). Innovative strategies like antimicrobial peptides and bacteriophages are urgently needed to improve outcome for patients with these complex infections.
More information:
Staphylococcus aureus colonization and infection
Methicillin-resistant Staphylococcus aureus (MRSA) colonization leads to increased infection rates and mortality. Optimizing the ‘search and destroy’ policy is of importance to maintain a low prevalence in the Netherlands.
Through MRSA Network Holland West we work together with our regional and national partners on different MRSA research projects, ranging from national surveys to whole genome sequencing of the MRSA isolates. The CLEANEST study, a cluster randomized multicentre study aims to identify the most effective treatment for MRSA eradication.
Staphylococcus aureus blood stream infection, both MSSA and MRSA are associated with high morbidity and mortality rates. We co-initiated and participate in the SAFE-trial, which investigates the safety of shortening the antibiotic treatment. Furthermore we aim to gain more insight into complications of S. aureus bacteraemia, such as metastatic infection and acute kidney injury.
Antifungal resistance and antifungal therapy
Aspergillus can cause invasive and non-invasive disease depending on the immune status of the host. In the past invasive aspergillosis was mostly seen in patients with neutropenia, but more recently invasive aspergillosis is also seen in non-neutropenic patients, such as patients with COVID-19 (COVID-19 associated pulmonary aspergillosis). Triazoles are the first choice treatment for invasive aspergillosis, but high resistance rates are emerging worldwide and have been reported as well in our region.
Our aim is to gain more insight into clinical aspects of emerging risk groups (such as patients with COVID-19), diagnostics, antifungal resistance and new therapeutic strategies.
Within the LUMC research projects are performed in collaboration with all departments that are part of the Leiden University Center for Infectious Diseases (LU-CID), in collaboration with other departments united in the Leiden Fungal Infections Study Group. Furthermore, there is a close collaboration with the Dutch National Institute for Public Health and the Environment (RIVM) and Radboudumc (mycology reference laboratory).
AMR and Microbiome
By combining data from experimental animal models, experimental human models and patient data obtained from large multi-center clinical trials, we aim to perform pig-to-patient analyses of colonization resistance.
Our research team is highly interdisciplinary, including molecular biologists, bioinformaticians, veterinary scientists and clinicians. The team focusses primarily on colonization resistance, bringing together expertise ranging from pig farming to patient care, which enables the translation of findings and the design of universal interventions which may be applied in clinical care and farming industry
…By combining data from experimental animal models, experimental human models and patient data obtained from large multi-center clinical trials, we aim to perform pig-to-patient analyses of colonization resistance.
Our research team is highly interdisciplinary, including molecular biologists, bioinformaticians, veterinary scientists and clinicians. The team focusses primarily on colonization resistance, bringing together expertise ranging from pig farming to patient care, which enables the translation of findings and the design of universal interventions which may be applied in clinical care and farming industry
With the advent of faecal microbiota transplantation, the field of colonization resistance is rapidly expanding and has shown high potential. Transmission of major human pathogens, including MRSA and Clostridioides difficile, between farm animals and human hosts is frequent. To a certain extent, the reservoir of livestock and humans may even be considered a shared reservoir, without geographical barriers. This emphasizes the importance of a comprehensive one health approach.
Contriburing Scientists: Prof. dr. M. Roestenberg, Dr. W.K. Smits, Dr. M. Lambregts.